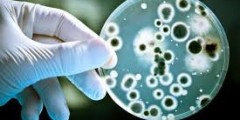

Տեխնոլոգիա




































Ամենադիտված
Այսօր
Այս շաբաթ
Այս ամիս